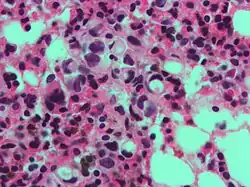

Células en anillo de sello
_PAS_stain.jpg)
.jpg)
En histología, una célula en anillo de sello es aquella célula con una vacuola grande. El tipo maligno se observa predominantemente en carcinomas.
Las células en anillo de sello están frecuentemente asociadas al cáncer de estómago,[1] pero puede surgir de distintos tejidos como la próstata, la vejiga, la vesícula biliar, la mama, el colon, el estroma ovárico y el testículo.[2][3][4][5]
Tipos
El NCI Thesaurus distingue diferentes tipos de "célula en anillo de sello" [6]
- Célula de castración, una célula no maligna que surge en la pituitaria anterior bajo ciertas condiciones hormonales anormales.
- Célula folicular en anillo de sello en neoplasia de la glándula tiroides
- Célula en anillo de sello de adenocarcinoma
- Célula en anillo de sello de melanoma
- Célula en anillo de sello estromal
Aspecto
El nombre de la célula proviene su aspecto; las células en anillo de sello aparentan ser anillos de sello . Contienen una gran cantidad de mucina, la cual empuja al núcleo hacia la periferia de célula. El contenido de mucina en las células en anillo de sello imita la apariencia de un agujero para el dedo y el núcleo imita aspecto de la cara del anillo en perfil.
Importancia diagnóstica
Un número significativo de células en anillo de sello, generalmente, se asocia con un pronóstico peor.[7][8]
Clasificación de carcinomas
Los carcinomas de células en anillo de sello pueden ser clasificados utilizando inmunohistoquímica.[9]
Véase también
- Carcinoma de células en anillo de sello
Referencias
- ↑ Cancer Research UK. Signet Ring Cancer. cancerhelp.org.uk. URL: http://www.cancerhelp.org.uk/help/default.asp?page=7581 Archivado el 14 de octubre de 2007 en Wayback Machine.. Accessed on: November 2, 2007.
- ↑ «Signet-ring carcinoma of the prostate». Pathol. Res. Pract. 192 (12): 1232-8; discussion 1239-41. 1996. PMID 9182294. doi:10.1016/S0344-0338(96)80156-7.
- ↑ «A case of ovarian metastasis of gallbladder carcinoma simulating primary ovarian neoplasm: diagnostic pitfalls and review of literature». Int. J. Gynecol. Cancer. 16 Suppl 1: 319-21. 2006. PMID 16515613. doi:10.1111/j.1525-1438.2006.00335.x.
- ↑ «Primary signet-ring cell carcinoma of the colon and rectum: report of eight cases and review of 154 Japanese cases». Hepatogastroenterology 53 (72): 845-9. 2006. PMID 17153438.
- ↑ «Primary signet-ring stromal tumor of the testis». Virchows Arch. 447 (1): 107-10. 2005. PMID 15909171. doi:10.1007/s00428-005-1218-2.
- ↑ «Signet ring cell». NCI Thesaurus (en inglés). Consultado el 29 de septiembre de 2020.
- ↑ «Treatment outcomes in patients with signet ring cell carcinoma of the colorectum». Am. J. Surg. 194 (3): 294-8. 2007. PMID 17693269. doi:10.1016/j.amjsurg.2006.12.041.
- ↑ Gastric Cancer: Practice Essentials, Background, Anatomy. 22 de abril de 2020. Consultado el 29 de septiembre de 2020.
- ↑ «Phenotypic classification of gastric signet ring cell carcinoma and its relationship with clinicopathologic parameters and prognosis». World J. Gastroenterol. 13 (23): 3189-98. 2007. PMID 17589897.
Enlaces externos
- Esta obra contiene una traducción total derivada de «Signet ring cell» de Wikipedia en inglés, concretamente de esta versión, publicada por sus editores bajo la Licencia de documentación libre de GNU y la Licencia Creative Commons Atribución-CompartirIgual 4.0 Internacional.